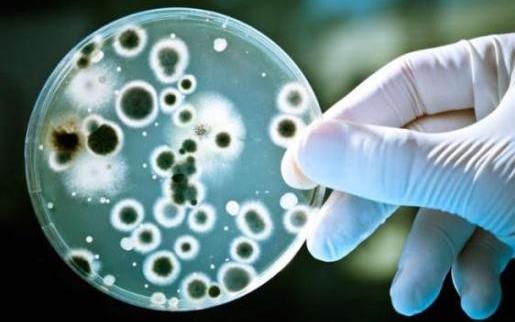

2013年,法國一個研究小組在智利中部海岸10米深的河流沈積物中採集到了一種寄生在變形蟲體內的非常罕見的病毒。在澳大利亞墨爾本附近的一個薄水池底部的泥漿中也發現了類似的病毒。後來,在馬賽、奴美阿、墨爾本和德國發現了這種病毒,有6名成員是同一種病毒。這種病毒的發現讓科學家們感到驚訝,因為它確實很大,比普通病毒大幾十倍,比一些細菌還大。有一種金黃色葡萄球菌,直徑為0.5~1.0μm,直接超過1μm,在普通顯微鏡下很容易看到。最令人費解的是,病毒實際上有93%的未知基因功能。

這些基因不同於地球上所有生物的基因,這意味著這些基因功能從未在地球上出現過,甚至是類似的功能。而且這種病毒的基因組中有很多內含子,這進一步增加了其基因組的複雜性,那麼內含子是什麼呢?內含子存在於各種生物體的已知基因中,在調控基因表達和參與基因進化中起這種要作用。沒有參考資料的對比,科學家們沒有辦法研究這種病毒,也很難追蹤其起源和進化。
有很多未知和恐懼。科學家們害怕在研究潘多拉魔盒後打開它會釋放出災難和瘟疫。這種病毒叫做潘多拉病毒。科學家曾經懷疑這種病毒來自另一個星球。由於潘多拉病毒的特殊性,建議將其分為一個不同於細菌、古細菌和真核生物三個域系統的域。目前,由於它在一定程度上仍符合經典病毒的特徵,如含有一種核酸,不能獨立進行能量代謝,不能自我分裂和增殖,在宿主細胞中表現出生命特徵等,所以被歸為病毒類。屬於經典病毒的基本形態。

潘多拉病毒中93%的未知基因在同一個地方起作用。這些基因是自己擁有的,我們稱之為“孤兒基因”,孤兒基因在生物體中扮演著更重要的角色。例如,昆蟲中有一種基因可以幫助它們產生“肌翼蛋白”,從而進化出飛行的翅膀。水母體內還有一種基因,可以幫助形成“蟄刺細胞”,讓水母射出一個充滿毒液的膠囊,攻擊獵物,使其昏迷不醒。這種不同於其他物種的獨特功能,來源於“孤兒基因”。

我們人類、黑猩猩和大猩猩是近親,其中有54種人類特有的“孤兒基因”。這些基因還很年輕,有2500萬年的歷史(相對於生命進化史)。它們的出現促進了人類大腦的迅速進化,最終人類進化出的智能遠遠超過其他靈長類動物。”“孤兒基因”是從其他基因複製而來的。它們形成後,迅速進化,最終所有與源基因相似的特徵消失。科學家對果蠅進行了實驗和觀察,發現其“孤兒基因”的進化速度是其他基因的3倍。孤兒基因在生物體內存在已久。到目前為止,在所有生物體中都發現了30%以上的孤兒基因。基因之間的“親緣關係”被證明是一個例外。









